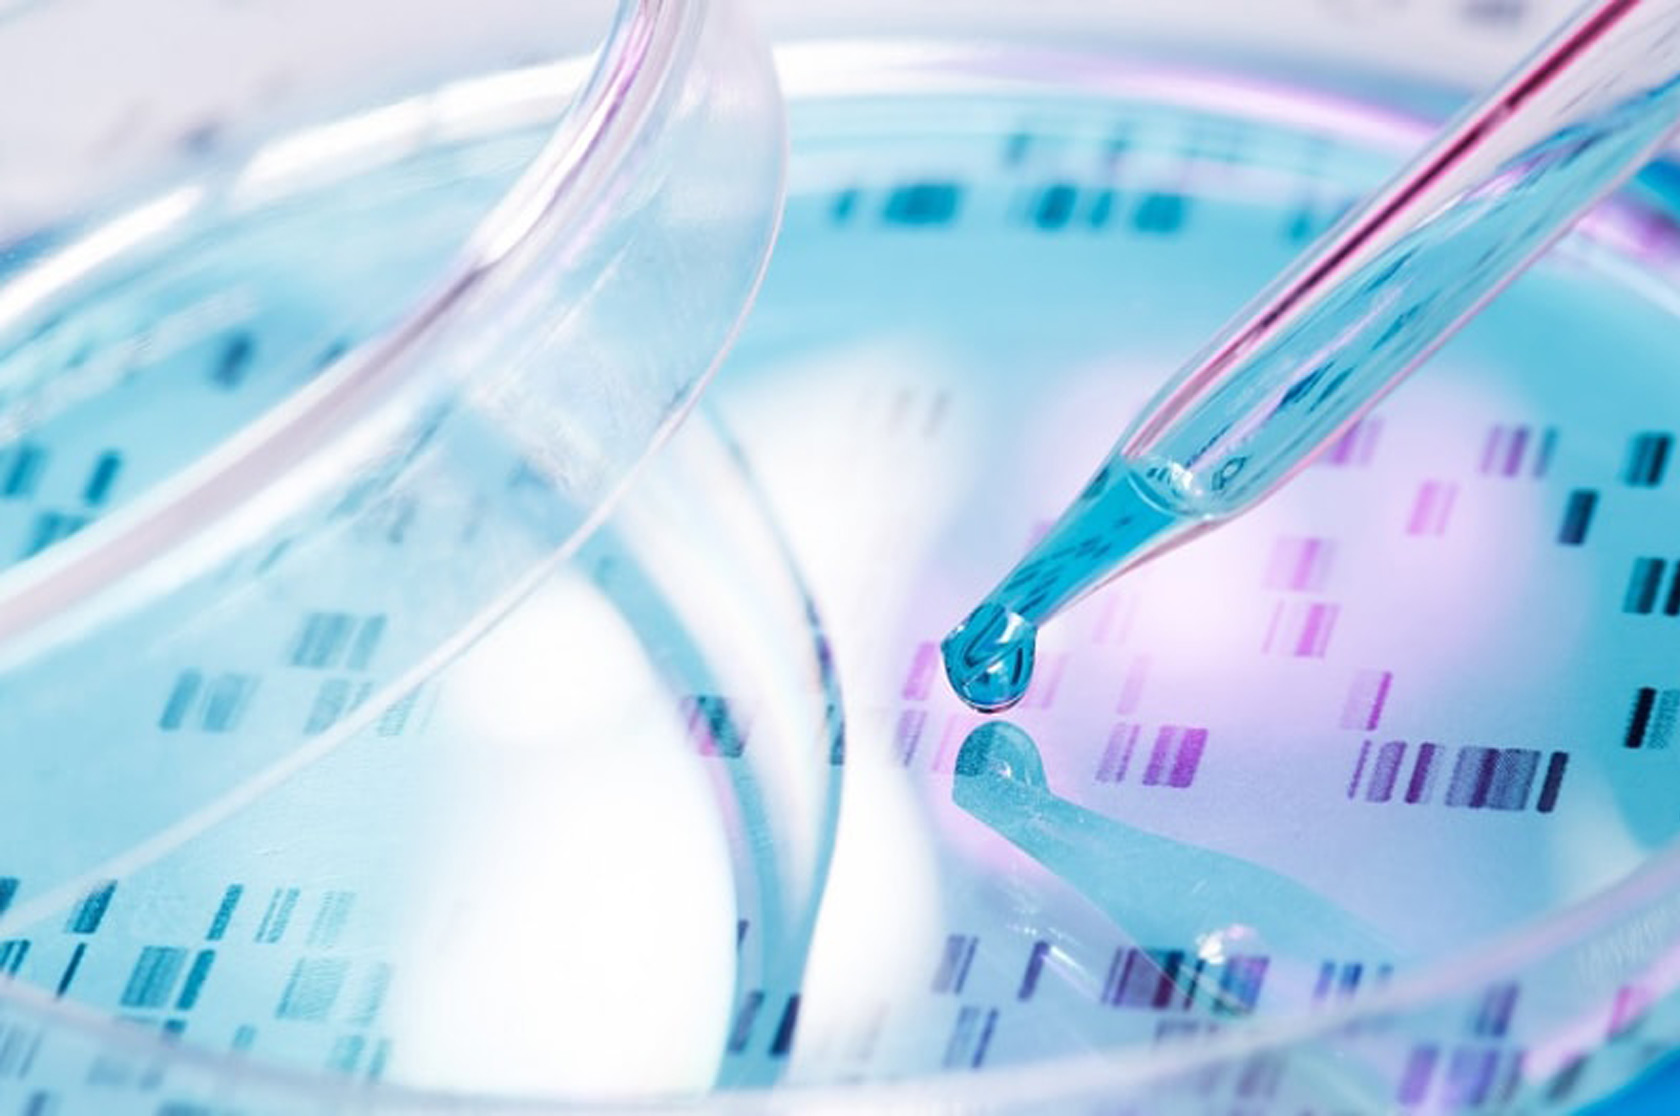

Giriş
Evinizdə qısa bir gəzintiyə çıxaq və həyatınızı asanlaşdıracaq nə qədər çox şeyin əvvəlcədən düşünülərək istifadənizə təqdim edildiyini bir düşünək... Hələ siz qapıdan addımınızı atmadan ayaqlarınızı silmək üçün yerləşdirilmiş ayaqaltı, içəri girdiyinizdə paltonuzu və ya pencəyinizi asacağınız bir asılqan, ayaqqabılarınızı qoyacağınız bir ayaqqabı yeri hazır vəziyyətdədir. Salonda oturacaqlar, xalça, pərdə, televizor kimi estetik və istifadəsindən rahatlığı düşünülərək yerləşdirilmiş əşyalar; mətbəxdə soyuducu, soba, içi bir çox lazımlı məmulatla dolu olan şkaflar tam ehtiyacınızı qarşılayacaq şəkildə hazır olarlar. Eyni şəkildə iş masası, lampa, qarderob və kitab rəfi... Hamısının yerbəyer edilməsinin məqsədi vardır.
Davamı
Maddənin fövqündəki şüur və materiyanın iflası
Maddənin fövqündəki şüur və materiyanın iflası
Materialist fəlsəfənin yayılmasından əvvəl elm dünyası Allahın kainatı və içindəki varlıqları yoxdan yaratdığını və hər an qüdrəti altında saxladığını qəbul edirdi. Materializm isə əvvəlcə Allahın təbiət üzərindəki daimi hökmranlığını rədd etdi. "Materiya" olaraq bilinən fəlsəfi baxış kainatdakı və təbiətdəki bütün sistemlərin öz-özünə işləyən bir maşın kimi olduğu iddiasıyla ortaya çıxdı. Materiyanın XVIII əsrdəki qabaqcıl nümayəndələrindən biri də Fransız Pierre Simon de Laplacedir.
Hüceyrə
İnsan bədənini meydana gətirən 100 trilyona yaxın hüceyrə heç dayanmadan və yorulub fasilə vermədən saysız fəaliyyət həyata keçirir. Orqanların və toxumaların vəzifələrini yerinə yetirə bilmələri, insanın gündəlik həyatını davam etdirə bilməsi, bu hüceyrələrin hər birinin vəzifəsini əskiksiz yerinə yetirməsi və tam bir uyğunluq içində işləməsi ilə mümkündür.
Hər canlının yaşaya bilməsi üçün enerjiyə və buna görə də qidaya ehtiyacı olduğu kimi, hüceyrə də saysız funksiyasını reallaşdıra bilmək üçün müxtəlif qida maddələrinə ehtiyac duyar.

Bədənimizi əhatə edən miniatür fabrik: Hüceyrə

Hüceyrənin mürəkkəb quruluşu təsadüflərlə izah oluna bilməz
Hüceyrənin mürəkkəb quruluşu təsadüflərlə izah oluna bilməz
Bir çox elm adamı hüceyrənin mürəkkəb quruluşunu, reallaşdırdığı məlumat və plan tələb edən əməliyyatları təsvir edə bilmək üçün bəzi bənzətmələr etmişlər. Bəziləri hüceyrəni xüsusi olaraq hazırlanmış kosmik gəmilərlə, bəziləri ən inkişaf etmiş şəhər mərkəzləri, bəziləri isə ən texnoloji mühitdən belə daha irəli səviyyədəki laboratoriya mühitləriylə müqayisə edirlər. Ancaq hər dəfə bu bənzətmələrin ardından, hüceyrənin bütün izah olunanlardan daha çox mürəkkəb olduğunu ifadə edirlər.
Hüceyrə membranının quruluşundakı üstün dizayn
Hüceyrə membranı hüceyrəni əhatə edən, incə və elastik bir quruluşdur. Bir neçə molekul, digər bir sözlə 7.5-10 nanometr (metrin milyardda biri) qalınlığındadır. Bir kağız qalınlığı qədər olması üçün, 10 mindən çox hüceyrə membranını üst-üstə yığmaq lazımdır. Ən əsas məlumatlara sahib bir kimsə üçün hüceyrə membranı, hüceyrəni xarici mühitdən qoruyan bir sərhəddir. Ancaq hüceyrə membranı elm adamlarının hələ XX əsrin sonlarında kəşf etdiyi bir çox kompleks xüsusiyyətə və vəzifəyə sahibdir.

Hüceyrə membranının quruluşundakı üstün dizayn

Hüceyrə membranındakı kompleks daşıma sistemləri
Hüceyrə membranındakı kompleks daşıma sistemləri
Hər hansı bir səbəblə qana qarışan bir maddə hüceyrə membranına gəldiyi zaman dərhal hüceyrə içinə girə bilməz. Böyüklüyünə, kimyəvi xüsusiyyətlərinə, faydalı və ya zərərli olmasına görə fərqli formalarda qarşılanar. Eynilə bir ölkənin sərhəd keçid məntəqələrindəki yoxlanış kimi hüceyrəyə daxil olacaq bir maddə də ciddi yoxlanışdan keçər. Əgər gələn yad bir maddədirsə, şəxsiyyət təsbiti edilər və təhlükəsizliyi təhdid etdiyinə qərar verilərsə deportasiya edilər. Lakin bəzi maddələrin giriş-çıxışı -bir ölkənin öz vətəndaşlarına tətbiq etdiyi asanlıq ...
Hüceyrə membranındakı zülal kanallarının seçib-keçirməsi
Zülallar hüceyrə daxilində sərbəst hərəkət edə bilməzlər, əksinə hüceyrə daxilindəki hərəkətləri son dərəcə ciddi nəzarət altındadır. Bir evin otaqlarında olduğu kimi, hüceyrənin də bölmələri vardır. Hüceyrə bölmələrinin divarları da "qapı" və kimyəvi "qəbuledici"lərlə təchiz olunmuşdur. Əgər doğru "identifikasiya koduna" sahib bir zülal yaxınlaşarsa, qəbuledici qapını açar və zülalın aradan keçməsinə icazə verər. Əgər səhv etiketli bir zülal gələrsə, qapı bağlı qalar.

Hüceyrə membranındakı zülal kanallarının seçib-keçirməsi

Sinir hüceyrələrindəki seçicilik
Sinir hüceyrələrindəki seçicilik
Neyron adı verilən sinir hüceyrələri digər hüceyrələrdən fərqli olaraq dendrit və akson deyilən hissələrə malikdir. Dendrit çox sayda qısa çıxıntıdan ibarətdir və hüceyrənin kökləri kimidir. Dendritlərin şaxələnmiş quruluşu digər neyronlardan və qəbuledici hüceyrələrindən siqnalların alınması və hüceyrənin cisminə çatdırılmasında xüsusi əhəmiyyətə malikdir. Aksonlar isə hüceyrənin cismindən çıxan uzun, bütöv bir hissədən ibarət olan, siqnalların göndərildiyi incə liflərdir və beyinə mesajların (impulsların) daşınmasına xidmət edərlər. Sinir hüceyrələri bu uzun zəncirlərdən ibarət olan sıx bir şəbəkə kimidir.
Hüceyrələr arasındakı məlumat hərəkətində siqnal seçimi
Bədənimizin daxilində hər an yüzlərlə mesaj bir tərəfdən digər tərəfə sanki qaçırmışcasına irəliləyər. Hüceyrələr bütün bu məlumat hərəkəti içərisində doğru seçimləri edə bilmək və özlərini maraqlandıran məlumatları aradan ala bilmək üçün son dərəcə kompleks tanıyıcı sistemlərlə təchiz edilmişlər. Məlumatlara aid şifrələr, zəncirvari bir kimyəvi çevrilmə nəticəsində tərcümə edilər.

Hüceyrələr arasındakı məlumat hərəkətində siqnal seçimi

Müdafiə sistemi hüceyrələrindəki seçim
Müdafiə sistemi hüceyrələrindəki seçim
Mikro düşmənlərimiz bədənin özünə aid olmayıb, bir yolla bədənə girən, bu səbəbdən bədəndəki müdafiə ordusunu hərəkətə keçirən mikro canlılardır. Şübhəsiz, bədənə girən hər xarici maddəyə dərhal düşmən münasibəti göstərilməz. Yemək yeyərkən, dərman qəbul edərkən, su içərkən də bədənimizə yad xüsusiyyəti olan maddələr girər. Ancaq bədənimiz bunlarla bir mübarizəyə girməz. Yad bir maddənin müdafiə hüceyrələri tərəfindən düşmən olaraq qəbul edilməsi üçün bəzi şərtlər meydana gəlməlidir: Molekul böyüklüyü, bədəndən atılma sürəti, bədənə daxil olma forması kimi...
Qandakı həyati seçim
Qanın həyati xüsusiyyətlərindən biri tərkibində olan zülallardır. Bədənin hər nöqtəsinə çatan damar sistemi sayəsində qanın içindəki zülallar da bədəndə ehtiyac duyulan hər bölgəyə çatmaq imkanına sahib olar. Məsələn, hemoqlobin adındakı zülal qandakı oksigeni toxumalara daşıyarkən, transferin adlı zülal isə qanda olan dəmiri daşıyar. İmmunoqlobulinlər bakteriya və viruslara qarşı bədəni qoruyan zülallardır. Fibrinogen və trombin qanın laxtalanmasını təmin edər. İnsulin bədəndəki şəkərin miqdarını tənzimləyən bir zülal növüdür. Hamısı bir-birindən əhəmiyyətli olan bu zülallar qan vasitəsilə aidiyyatı toxumalara çatdırılar.

Qandakı həyati seçim

Hüceyrə membranındakı dizaynın çox hüceyrəlilik baxımından əhəmiyyəti
Hüceyrə membranındakı dizaynın çox hüceyrəlilik baxımından əhəmiyyəti
Tipik bir hüceyrənin səthi, düz deyil nahamardır. Bir çox hüceyrə, səthlərindəki filopod olaraq adlandırılan mikro-çıxıntılar vasitəsilə bir-birlərinə təmas edərlər. Bunların uzunluğu çox vaxt 0,1 mikron qədərdir və bir mikron kvadrat sahənin yüzdə biri qədərini örtər. Bu mikro-çıxıntıları insanın barmaqları kimi istifadə edən hüceyrə, olduğu mühiti öyrənər və yaxın ətrafındakı digər hüceyrələrin səthlərini “hiss edər”.
Bədəndə seçilən maddələrin həssas tarazlığı
Hüceyrə öz içinə alacağı materialların seçilməsində fövqəladə həssasdır. Hüceyrə ancaq önünə gələn bir maddənin özünə faydalı, yaxud zərərli olacağını təsbit etdikdən sonra bu maddəni içərisinə alar. Ancaq burada soruşulmalı olan bir sual var: Bu seçimi kim edir? Cavabı təsadüf kimi ağıl və məntiqdən kənar bir şərhə sığdırmağa çalışmaq isə şübhəsiz həqiqətlərdən qaçmaqdır.

Bədəndə seçilən maddələrin həssas tarazlığı

Hüceyrə membranı təkamül nəzəriyyəsinin iddialarını etibarsız edir
Hüceyrə membranı təkamül nəzəriyyəsinin iddialarını etibarsız edir
Təkamülçülərin ilk canlı hüceyrəsinin mənşəyini izah edən ssenarilərinə görə canlılıq “ibtidai bir şorba” da, yəni bəzi üzvi molekulların bir yerdə olduğu maye mühitində başlamışdı. Bir çox təkamülçü bu ibtidai şorbanın okeanlar və ya göllər olduğunu irəli sürür. Bəhsi keçən ssenaridə ibtidai şorbanın içindəki sadə üzvi molekullar amin turşularını meydana gətirmişlər, daha sonra bunlar zülalları meydana gətirərək öz-özünü köçürə bilən molekullara çevrilmişlər.
Nəticə
Bir çox insanın öz bədənində olub bitənlər haqqında məlumatı son dərəcə azdır. Xəstələnib müalicə almalı olduğu vaxta qədər, nə qədər çox şeyin özü üçün əvvəlcədən düşünülmüş olduğunun fərqində olmadan həyatını davam etdirir. Bir gün bir narahatlıq hiss etməsinə qədər bədənindəki heç bir şeyi nəzarətdə saxlamasına, işləyib işləmədiyindən narahat olmasına gərək yoxdur.
Hüceyrə membranı insanın həyatını davam etdirə bilməsi üçün yaradılmış saysız incəlikdən yalnızca biridir.

Nəticə: Allah elmi ilə hər yeri əhatə edəndir
